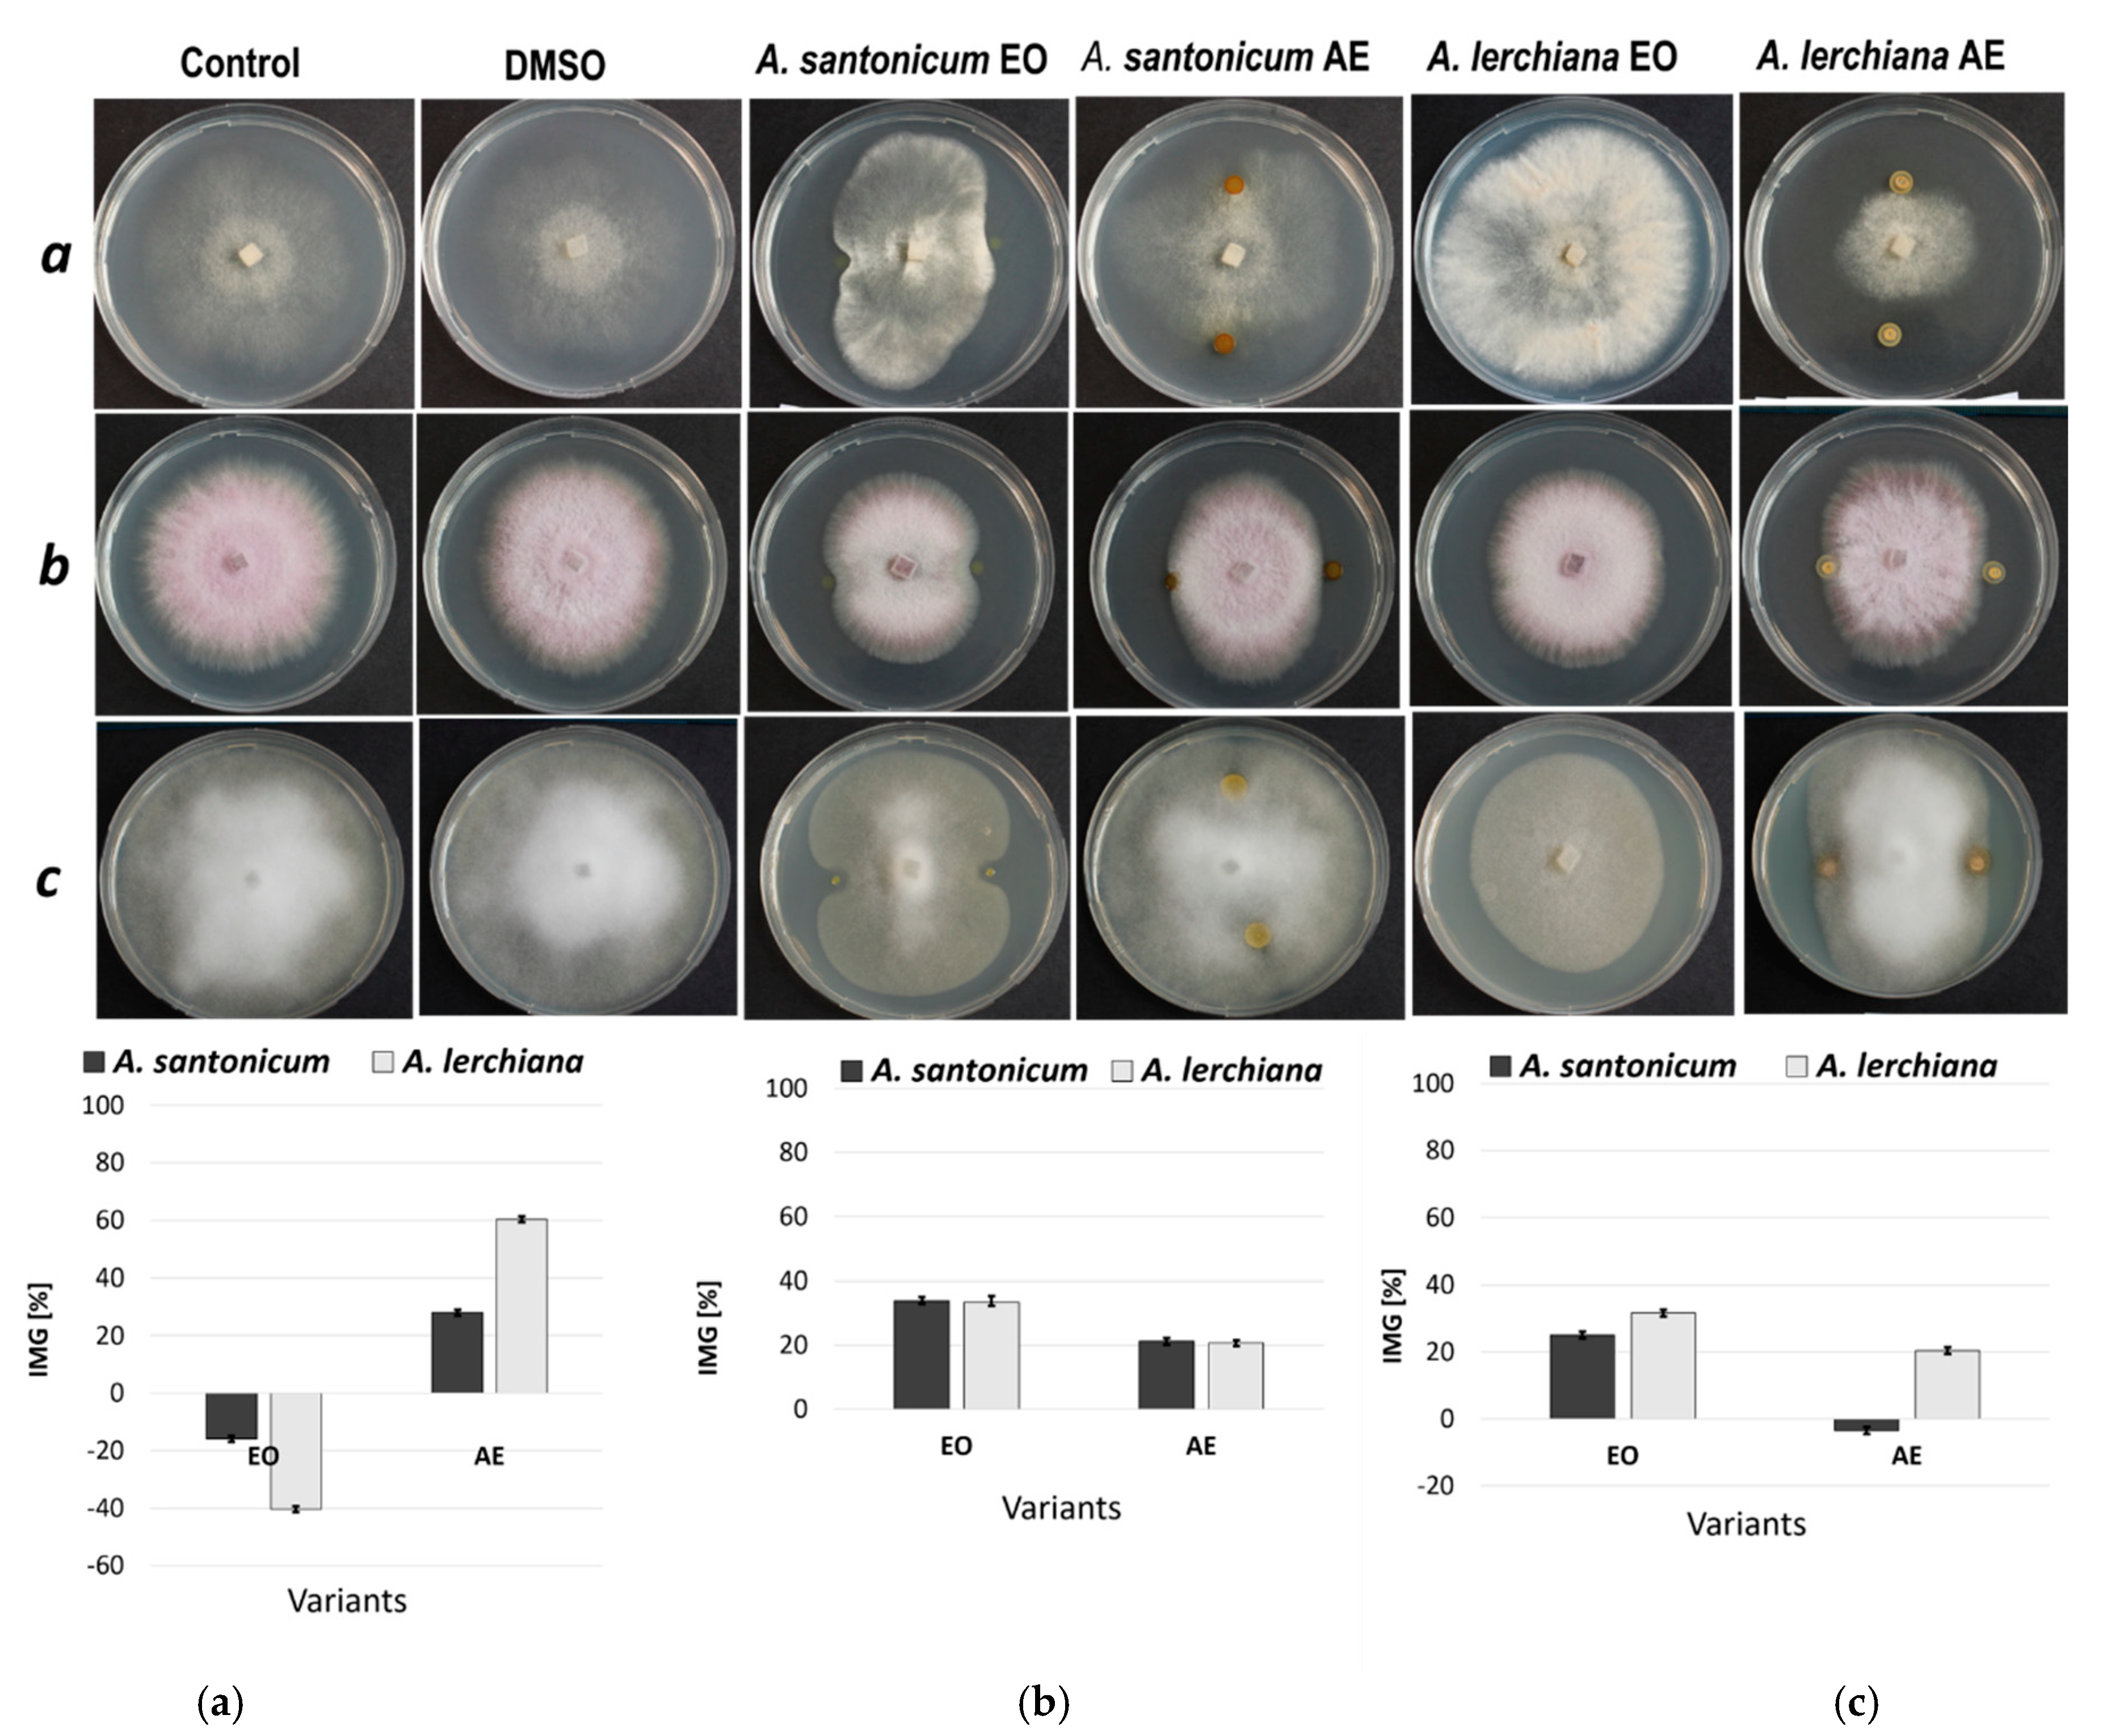
Plants 12 03491 g002 Plants 12 03491 g002

Artemisia santonicum L. and Artemisia lerchiana Web. Essential Oils and Exudates as Sources of Compounds with Pesticidal Action
Abstract
1. Introduction
2. Results
2.1. Phytochemical Analysis
2.2. Inhibition of Seed Germination
2.3. Inhibition of Acetylcholinesterase (AChE)
2.4. Inhibition of Phytopathogenic Mycelium Growth
3. Discussion
3.1. Phytochemical Analysis
3.2. Inhibition on Seed Germination
3.3. Inhibition of Acetylcholinesterase (AChE)
3.4. Inhibition of Phytopathogenic Mycelium Growth
4. Materials and Methods
4.1. Plant Material
4.2. Extraction Procedures
4.3. Derivatization of the Exudates
4.4. GC/MS Analysis
4.5. Preparation of Fractions (EO and AE) before Bioassays
4.6. Inhibition on Seed Germination
4.7. Inhibition of Acetylcholinesterase (AChE)
4.8. Inhibition of Phytopathogenic Mycelium Growth
4.9. Data Analysis
5. Conclusions
Author Contributions
Funding
Data Availability Statement
Acknowledgments
Conflicts of Interest
References
- Okwute, S.K. Plants as Potential Sources of Pesticidal Agents: A Review. In Pesticides—Advances in Chemical and Botanical Pesticides; Soundararajan, R.P., Ed.; InTech: London, UK, 2012; pp. 207–232. [Google Scholar] [CrossRef]
- Cai, X.; Gu, M. Bioherbicides in Organic Horticulture. Horticulturae 2016, 2, 3. [Google Scholar] [CrossRef]
- Saroj, A.; Oriyomi, O.V.; Nayak, A.K.; Haider, S.Z. Phytochemicals of Plant-Derived Essential Oils: A Novel Green Approach Against Pests. In Natural Remedies for Pest, Disease and Weed Control; Egbuna, C., Sawicka, B., Eds.; Academic Press: Cambridge, MA, USA, 2020; pp. 65–79. [Google Scholar] [CrossRef]
- Lengai, G.M.W.; Muthomi, J.W.; Mbega, E.R. Phytochemical activity and role of botanical pesticides in pest management for sustainable agricultural crop production. Sci. Afr. 2020, 7, e00239. [Google Scholar] [CrossRef]
- Ngegba, P.M.; Cui, G.; Khalid, M.Z.; Zhong, G. Use of Botanical Pesticides in Agriculture as an Alternative to Synthetic Pesticides. Agriculture 2022, 12, 600. [Google Scholar] [CrossRef]
- Saini, R.; Singh, S. Use of natural products for weed management in high-value crops: An Overview. Am. J. Agric. Biol. Sci. 2019, 4, 25. [Google Scholar] [CrossRef][Green Version]
- Shanmugalingam, S.; Umarukatha, J.B. Review on Use of Plant Extracts in Weed Control. Curr. Trends Biomed. Eng. Biosci. 2019, 18, 555993. [Google Scholar] [CrossRef]
- Werrie, P.-Y.; Durenne, B.; Delaplace, P.; Fauconnier, M.-L. Phytotoxicity of Essential Oils: Opportunities and Constraints for the Development of Biopesticides. A Review. Foods 2020, 9, 1291. [Google Scholar] [CrossRef] [PubMed]
- Ayilara, M.S.; Adeleke, B.S.; Akinola, S.A.; Fayose, C.A.; Adeyemi, U.T.; Gbadegesin, L.A.; Omole, R.K.; Johnson, R.M.; Uthman, Q.O.; Babalola, O.O. Biopesticides as a promising alternative to synthetic pesticides: A case for microbial pesticides, phytopesticides, and nanobiopesticides. Front. Microbiol. 2023, 14, 1040901. [Google Scholar] [CrossRef] [PubMed]
- Ibáñez, M.D.; Blázquez, M.A. Phytotoxicity of Essential Oils on Selected Weeds: Potential Hazard on Food Crops. Plants 2018, 7, 79. [Google Scholar] [CrossRef]
- Raveau, R.; Fontaine, J.; Lounès-Hadj Sahraoui, A. Essential Oils as Potential Alternative Biocontrol Products against Plant Pathogens and Weeds: A Review. Foods 2020, 9, 365. [Google Scholar] [CrossRef]
- Jouini, A.; Verdeguer, M.; Pinton, S.; Araniti, F.; Palazzolo, E.; Badalucco, L.; Laudicina, V.A. Potential Effects of Essential Oils Extracted from Mediterranean Aromatic Plants on Target Weeds and Soil Microorganisms. Plants 2020, 9, 1289. [Google Scholar] [CrossRef]
- Verdeguer, M.; Sánchez-Moreiras, A.M.; Araniti, F. Phytotoxic Effects and Mechanism of Action of Essential Oils and Terpenoids. Plants 2020, 9, 1571. [Google Scholar] [CrossRef] [PubMed]
- Garrido-Miranda, K.A.; Giraldo, J.D.; Schoebitz, M.S. Essential Oils and Their Formulations for the Control of Curculionidae Pests. Front. Agron. 2022, 4, 876687. [Google Scholar] [CrossRef]
- Gikonyo, N.; Mwangi, R.; Ogweno Midiwo, J. Toxicity and growth-inhibitory activity of Polygonum senegalense (Meissn.) surface exudate against Aedes aegypti larvaeInt. J. Trop. Insect Sci. 1998, 18, 229–234. [Google Scholar] [CrossRef]
- Chaves, N.; Sosa, T.; Escudero, J. Plant growth inhibiting flavonoids in exudate of Cistus ladanifer and in associated soils. J. Chem. Ecol. 2001, 27, 623e631. [Google Scholar]
- Alcerito, T.; Barbo, F.E.; Negri, G.; Santos, D.-Y.-A.-C.; Meda, C.-I.; Young, C.-M.; Chávez, D.; Blatt, C.-T.-T. Foliar epicuticular wax of Arrabidaea brachypoda: Flavonoids and antifungal activity. Biochem. Syst. Ecol. 2002, 30, 677–683. [Google Scholar] [CrossRef]
- Onyilagha, J.; Grotewold, E. The biology and structural distribution of surface flavonoids. In Recent Research Developments in Plant Science; Pandalai, S.G., Ed.; Research Signpost: Trivandrum, India, 2004; pp. 53–71. [Google Scholar]
- Lahtinen, M.; Salminen, J.P.; Kapari, L.; Lempa, K.; Ossipov, V.; Sinkkonen, J.; Valkama, E.; Haukioja, E.; Pihlaja, K. Defensive effect of surface flavonoid aglycones of Betula pubescens leaves against first instar Epirrita autumnata larvae. J. Chem. Ecol. 2004, 30, 2257–2268. [Google Scholar] [CrossRef] [PubMed]
- Montenegro, I.; Valenzuela, M.; Zamorano, N.; Santander, R.; Baez, C.; Madrid, A. Activity of Adesmia boronioides resinous exudate against phytopathogenic bacteria. Nat. Prod. Res. 2021, 12, 2072–2075. [Google Scholar] [CrossRef] [PubMed]
- Zygadlo, J.A.; Guzman, C.A.; Grosso, N.R. Antifungal Properties of the Leaf Oils of Tagetes minuta L. and T. filifolia Lag. J. Essent. Oil Res. 1994, 6, 617–621. [Google Scholar] [CrossRef]
- Watanabe, Y.; Novaes, P.; Varela, R.M.; Molinillo, J.M.; Kato-Noguchi, H.; Macías, F.A. Phytotoxic potential of Onopordum acanthium L. (Asteraceae). Chem. Biodivers. 2014, 11, 1247–1255. [Google Scholar] [CrossRef]
- Ivănescu, B.; Burlec, A.F.; Crivoi, F.; Roșu, C.; Corciovă, A. Secondary Metabolites from Artemisia Genus as Biopesticides and Innovative Nano-Based Application Strategies. Molecules 2021, 26, 3061. [Google Scholar] [CrossRef]
- Benvenuti, S.; Cioni, P.L.; Flamini, G.; Pardossi, A. Weeds for weed control: Asteraceae essential oils as natural herbicides. Weed Res. 2017, 57, 342–353. [Google Scholar] [CrossRef]
- Zhang, J.W.; Li, B.Y.; Lu, X.X.; Zheng, Y.; Wang, D.; Zhang, Z.; Zeng, D.; Du, S.S. Chemical Diversity and Anti-Insect Activity Evaluation of Essential Oils Extracted from Five Artemisia Species. Plants 2022, 11, 1627. [Google Scholar] [CrossRef] [PubMed]
- Shahrajabian, M.H.; Sun, W.; Cheng, Q. Spanish chamomile (Anacyclus pyrethrum) and pyrethrum (Tanacetum cineraiifolium): Organic and natural pesticides and treasure of medicinal herbs. Not. Sci. Biol. 2021, 13, 10816. [Google Scholar] [CrossRef]
- Singh, H.P.; Kaur, S.; Mittal, S.; Batish, D.R.; Kohli, R.K. Essential oil of Artemisia scoparia inhibits plant growth by generating reactive oxygen species and causing oxidative damage. Chem. Ecol. 2009, 35, 154–162. [Google Scholar] [CrossRef] [PubMed]
- Kaur, S.; Singh, H.P.; Mittal, S.; Batish, D.R.; Kohli, R.K. Phytotoxic effects of volatile oil from Artemisia scoparia against weeds and its possible use as a bioherbicide. Ind. Crops Prod. 2010, 32, 54–61. [Google Scholar] [CrossRef]
- Todorova, M.N.; Kuleva, L.V.; Christov, R.C.; Vitkova, A.A. Chemotypes of Artemisia Ierchiana Weber. from Bulgaria. J. Essent. Oil Res. 1997, 9, 299–301. [Google Scholar] [CrossRef]
- Kirichenko, E.B.; Orlova, Y.V.; Kurilov, D.V. Component composition of the essential oil of the Artemisia lerchiana Web. from the Southeastern Russia. Dokl. Biochem. Biophys. 2008, 422, 292–295. [Google Scholar] [CrossRef] [PubMed]
- Burzo, I.; Ciocârlan, V.; Delian, E.; Dobrescu, A.; Bădulescu, L. Researches regarding the essential oil composition of some Artemisia l. species. Sci. Ann. “Alexandru Ioan Cuza” Univ. Iasi Veg. Biol. 2008, 54, 86–91. [Google Scholar]
- Kordali, S.; Cakir, A.; Mavi, A.; Kilic, H.; Yildirim, A. Screening of chemical composition and antifungal and antioxidant activities of the essential oils from three Turkish Artemisia species. J. Agric. Food Chem. 2005, 53, 1408–1416. [Google Scholar] [CrossRef]
- Stanković Jeremić, J.; Novaković, M.; Tešević, V.; Ćirić, A.; Zdunić, G.; Dajić Stevanović, Z.; Gođevac, D. Antifungal activity of the essential oil from Artemisia santonicum and its constituent isogeranic acid. Lekovite Sirovine 2020, 40, 62–65. [Google Scholar] [CrossRef]
- Kordali, S.; Aslan, I.; Çalmaşur, O.; Cakir, A. Toxicity of essential oils isolated from three Artemisia species and some of their major components to granary weevil, Sitophilus granarius (L.) (Coleoptera: Curculionidae). Ind. Crops Prod. 2006, 23, 162–170. [Google Scholar] [CrossRef]
- Dadasoglu, F.; Kotan, R.; Cakir, A.; Cakmakei, R.; Kordali, S.; Ozer, H.; Karagoz, K.; Dikbas, N. Antibacterial activities of essential oils extracts and some of their major components of Artemisia spp. L. against seed-borne plant pathogenic bacteria. Fresenius Environ. Bull. 2015, 24, 2715–2724. [Google Scholar]
- Badea, M.L.; Delian, E. In vitro antifungal activity of the essential oils from Artemisia spp. L. on Sclerotinia sclerotiorum. Rom. Biotechnol. Lett. 2014, 19, 9345–9352. [Google Scholar]
- Nikolova, M.T.; Aneva, I.Y.; Dimitrova, M.N.; Berkov, S.H. Metabolic profiling of Artemisia santonicum and Artemisia lerchiana by GC/MS. Probl. Biol. Med. Pharm. Chem. 2019, 22, 26. [Google Scholar] [CrossRef]
- Sotirova, A.; Mutafova, B.; Berkov, S.; Nikolova, M. Antibacterial activity of extracts and exudates from Bulgarian medicinal plants. Acta Microbiol. Bulg. 2022, 38, 48–51. [Google Scholar]
- Lopez, M.D.; Pascual-Villalobos, M.J. Mode of inhibition of acetylcholinesterase by monoterpenoids and implications for pest control. Ind. Crops Prod. 2010, 31, 284–288. [Google Scholar] [CrossRef]
- Mladenović, M.; Arsić, B.B.; Stanković, N.; Mihović, N.; Ragno, R.; Regan, A.; Milićević, J.S.; Trtić- Petrović, T.M.; Micić, R. The targeted pesticides as acetylcholinesterase inhibitors: Comprehensive cross-organism molecular modelling studies performed to anticipate the pharmacology of harmfulness to humans in vitro. Molecules 2018, 23, 2192. [Google Scholar] [CrossRef]
- Stanković, J.; Novaković, M.; Tešević, V.; Ćirić, A.; Soković, M.; Zdunić, G.; Dajić-Stevanović, Z.; Gođevac, D. HPTLC-direct bioautography-guided isolation of isogeranic acid as the main antibacterial constituent of Artemisia santonicum essential oil. J. Serb. Chem. Soc. 2019, 84, 1355–1365. [Google Scholar] [CrossRef]
- Ferrante, C.; Zengin, G.; Menghini, L.; Diuzheva, A.; Jekő, J.; Cziáky, Z.; Recinella, L.; Chiavaroli, A.; Leone, S.; Brunetti, L.; et al. Qualitative Fingerprint Analysis and Multidirectional Assessment of Different Crude Extracts and Essential Oil from Wild Artemisia santonicum L. Processes 2019, 7, 522. [Google Scholar] [CrossRef]
- Dítě, D.; Eliáš, P.; Melečková, Z. Artemisia santonicum subsp. patens in slovakia: The sad story of obligate halophyte on the northern edge of its distribution range. Hacquetia 2013, 12, 5–16. [Google Scholar] [CrossRef]
- Blázquez, M.A.; Carbó, E. Control of Portulaca oleracea by boldo and lemon essential oils in different soils. Ind. Crops Prod. 2015, 76, 515–521. [Google Scholar] [CrossRef]
- Nikolova, M.; Yovkova, M.; Yankova-Tsvetkova, E.; Traikova, B.; Stefanova, T.; Aneva, I.; Berkov, S. Biocidal Activity of Origanum vulgare subsp. hirtum Essential Oil. Acta Univ. Agric. Silvic. Mendel. Brun. 2021, 69, 569–578. [Google Scholar] [CrossRef]
- Amri, I.; Hanana, M.; Jamoussi, B.; Jamoussi, B. Essential oils of Pinus nigra J.F. Arnold subsp. laricio Maire: Chemical composition and study of their herbicidal potential. Arab. J. Chem. 2017, 10, S3877–S3882. [Google Scholar] [CrossRef]
- Angelini, L.G.; Carpanese, G.; Cioni, P.L.; Morelli, I.; Macchia, M.; Flamini, G. Essential oils from Mediterranean Lamiaceae as weed germination inhibitors. J. Agric. Food Chem. 2003, 51, 6158–6164. [Google Scholar] [CrossRef]
- Amri, I.; Hamrouni, L.; Hanana, M.; Jamoussi, B. Reviews on phytotoxic effects of essential oils and their individual components: News approach for weeds management. Int. J. Appl. Biol. Pharm. Technol. 2013, 4, 96–114. [Google Scholar]
- Fagodia, S.K.; Batish, D.R.; Singh, H.P. Phytotoxic assessment of some monoterpenes and their formulation with leaf extract of Chenopodium ambrosioides. NEHU J. 2020, 28, 41–56. [Google Scholar]
- Ben Kaab, S.; Lins, L.; Hanafi, M.; Bettaieb Rebey, I.; Deleu, M.; Fauconnier, M.L.; Ksouri, R.; Jijakli, M.H.; Clerck, C. Cynara cardunculus Crude Extract as a Powerful Natural Herbicide and Insight into the Mode of Action of Its Bioactive Molecules. Biomolecules 2020, 10, 209. [Google Scholar] [CrossRef]
- Dohi, S.; Terasaki, M.; Makino, M. Acetylcholinesterase inhibitory activity and chemical composition of commercial essential oils. J. Agric. Food Chem. 2009, 57, 4313–4318. [Google Scholar] [CrossRef]
- Seo, S.M.; Kim, J.; Kang, J.; Koh, S.H.; Ahn, Y.J.; Kang, K.S.; Park, I.K. Fumigant toxicity and acetylcholinesterase inhibitory activity of 4 Asteraceae plant essential oils and their constituents against Japanese termite (Reticulitermes speratus Kolbe). Pestic Biochem Physiol. 2014, 113, 55–61. [Google Scholar] [CrossRef]
- Picollo, M.I.; Toloza, A.C.; Mougabure Cueto, G.; Zygadlo, J.; Zerba, E. Anticholinesterase and pediculicidal activities of monoterpenoids. Fitoterapia 2008, 79, 271–278. [Google Scholar] [CrossRef]
- Kordali, S.; Kotan, R.; Mavi, A.; Cakir, A.; Ala, A.; Yildirim, A. Determination of the chemical composition and antioxidant activity of the essential oil of Artemisia dracunculus and of the antifungal and antibacterial activities of Turkish Artemisia absinthium, A. dracunculus, Artemisia santonicum, and Artemisia spicigera essential oils. J. Agric. Food Chem. 2005, 53, 9452–9458. [Google Scholar] [CrossRef]
- Soković, M.D.; Glamočlija, J.M.; Ćirić, A.D. Natural products from plants and fungi as fungicides. In Fungicides-Showcases of Integrated Plant Disease Management from around the World; Nita, M., Ed.; IntechOpen: London, UK, 2013; pp. 185–232. [Google Scholar]
- Lyubenova, A.; Rusanova, M.; Nikolova, M.; Slavtcho, B.S. Plant extracts and Trichoderma spp.: Possibilities for implementation in agriculture as biopesticides. Biotechnol. Biotechnol. Equip. 2023, 37, 159–166. [Google Scholar] [CrossRef]
- Krumova, E.; Nikolova, M.; Miteva-Staleva, J.; Kostadinova, N.; Abrashev, R.; Dishliyska, V.; Berkov, S.; Mutafova, B.; Angelova, M. Bio-efficacy of the essential oil isolated from Origanum vulgare subsp. hirtum against fungal pathogens of potato. C. R. Acad. Bulg. Sci. 2021, 74, 1571–1578. [Google Scholar]
- Trifan, A.; Zengin, G.; Sinan, K.I.; Sieniawska, E.; Sawicki, R.; Maciejewska-Turska, M.; Skalikca-Woźniak, K.; Luca, S.V. Unveiling the Phytochemical Profile and Biological Potential of Five Artemisia Species. Antioxidants 2022, 11, 1017. [Google Scholar] [CrossRef]
- Bordean, M.-E.; Ungur, R.A.; Toc, D.A.; Borda, I.M.; Marțiș, G.S.; Pop, C.R.; Filip, M.; Vlassa, M.; Nasui, B.A.; Pop, A.; et al. Antibacterial and Phytochemical Screening of Artemisia Species. Antioxidants 2023, 12, 596. [Google Scholar] [CrossRef]
- Chebbac, K.; Moussaoui, A.E.; Bourhia, M.; Salamatullah, A.M.; Alzahrani, A.; Guemmouh, R. Chemical Analysis and Antioxidant and Antimicrobial Activity of Essential oils from Artemisia negrei L. against Drug-Resistant Microbes. J. Evid. Based Complementary Altern. Med. 2021, 2021, 5902851. [Google Scholar] [CrossRef]
- Slavov, S.; Yordanov, P.; Nikolova, M. In vitro effect of plant extracts and exudates on mycelium growth of fungal plant pathogens. Bulg. J. Agric. Sci. 2021, 27, 682–687. [Google Scholar]
- Wollenweber, E. On the distribution of exudate flavonoids among angiosperms. Rev. Latinoamer. Quim. 1990, 21, 115–121. [Google Scholar]
- Wollenweber, E.; Dörr, M.; Rustaiyan, A.; Roitman, J.; Graven, E. Notes: Exudate Flavonoids of Some Salvia and a Trichostema Species. Z. Naturforsch. C 1992, 47, 782–784. [Google Scholar] [CrossRef][Green Version]
- Traykova, B.; Stanilova, M.; Nikolova, M.; Berkov, S. Growth and essential oils of Salvia officinalis plants derived from conventional or aeroponic produced seedlings. Agric. Consp. Sci. 2019, 84, 77–81. [Google Scholar]
- Berkov, S.; Pechlivanova, D.; Denev, R.; Nikolova, M.; Georgieva, L.; Sidjimova, B.; Bakalov, D.; Tafradjiiska, R.; Stoynev, A.; Momekov, G.; et al. GC-MS analysis of Amaryllidaceae and Sceletium-type alkaloids in bioactive fractions from Narcissus cv. Hawera. Rapid Commun. Mass Spectrom. 2021, 35, e9116. [Google Scholar] [CrossRef] [PubMed]
- Adams, R.P. Identification of Essential Oil Components by Gas Chromatography/Mass Spectroscopy, 4th ed.; Allured Publishing Corporation: Carol Stream, IL, USA, 2007; p. 804. [Google Scholar]
- Tkachev, A.V. Issledovanie Letuchikh Veshchestv Rastenii (Study of Volatile Substances of Plants); Ofset Publ.: Novosibirsk, Russia, 2008; p. 969. [Google Scholar]
- Atak, M.; Mavi, K.; Uremis, I. Bio-herbicidal effects of oregano and rosemary essential oils on germination and seedling growth of bread wheat cultivars and weeds. Rom. Biotechnol. Lett. 2016, 21, 11149–11159. [Google Scholar]
- López, S.; Bastida, J.; Viladomat, F.; Codina, C. Acetylcholinesterase inhibitory activity of some Amaryllidaceae alkaloids and Narcissus extracts. Life Sci. 2002, 71, 2521–2529. [Google Scholar] [CrossRef] [PubMed]
- Lyubenova, A.; Kostov, K.; Tsvetkov, I.; Slavov, S. Pathogens from the genus Phytophthora associated with fruit and forest species in Bulgaria. For. Sci. 2015, 51, 79–96. [Google Scholar]
- Jung, T.; Blaschke, M. Phytophthora root and collar rot of alders in Bavaria: Distribution, modes of spread and possible management strategies. Plant Pathol. 2004, 53, 197–208. [Google Scholar] [CrossRef]
- Balouiri, M.; Sadiki, M.; Ibnsouda, S.K. Methods for in vitro evaluating antimicrobial activity: A review. J. Pharm. Anal. 2016, 6, 71–79. [Google Scholar] [CrossRef] [PubMed]
- Schneider, C.A.; Rasband, W.S.; Eliceiri, K.W. NIH Image to ImageJ: 25 years of image analysis. Nat. Methods 2012, 9, Article 7. [Google Scholar] [CrossRef]

| RRI * | Compound | A. lerchiana | A. santonicum |
|---|---|---|---|
| 914 | 2-Methyl-2,5-divinyltetrahydrofuran | 0.8 | - |
| 929 | α-Thujene | 0.5 | - |
| 937 | α-Pinene | 0.3 | 9.3 |
| 952 | Camphene | 4.8 | - |
| 979 | β-Pinene | 0.3 | 15.2 |
| 991 | 2,3-Dehydro-1,8-cineole | 0.3 | - |
| 1017 | α-Terpinene | - | 0.1 |
| 1024 | p-Cymene- | 1.2 | 5.3 |
| 1028 | Limonene | - | 2.7 |
| 1032 | Eucalyptol (1,8-Cineole) | 22.1 | - |
| 1052 | cis-Arbusculone | 0.1 | - |
| 1060 | γ-Terpinene | 0.5 | 0.4 |
| 1065 | Acetophenone | - | 0.2 |
| 1070 | trans-Arbusculone | 0.1 | - |
| 1070 | cis-Sabinene hydrate | 0.6 | - |
| 1088 | Terpinolene | 0.4 | 0.9 |
| 1090 | p-Cymenene | 0.1 | 0.1 |
| 1098 | trans-Sabinene hydrate | 0.2 | - |
| 1125 | α-Campholenal | - | 0.8 |
| 1139 | trans-Pinocarveol | - | 9.6 |
| 1140 | trans-p-2-Menthen-1-ol | 0.1 | - |
| 1142 | cis-Verbenol | - | 0.1 |
| 1145 | Camphor | 14.0 | - |
| 1157 | Isoborneol | 0.1 | 2.1 |
| 1163 | Pinocarvone | - | 3.0 |
| 1165 | Borneol | 6.6 | - |
| 1178 | Terpinen-4-ol | 2.1 | 0.1 |
| 1189 | α-Terpineol | 1.3 | 9.2 |
| 1195 | Myrtenol | 1.0 | 0.1 |
| 1205 | Verbenone | - | 0.1 |
| 1208 | cis-Piperitol | 1.4 | - |
| 1217 | trans-Carveol | 1.4 | 0.6 |
| 1233 | cis-Carveol | 0.1 | - |
| 1242 | Carvone | 0.6 | 0.8 |
| 1254 | Piperitone | 0.6 | - |
| 1258 | Carvenone | 0.6 | - |
| 1283 | Lavandulyl acetate | 0.1 | - |
| 1285 | Bornyl acetate | 1.1 | 2.7 |
| 1297 | trans-Pinocarvyl acetate | - | 0.1 |
| 1292 | Thymol | 0.2 | 0.1 |
| 1302 | Carvacrol | 6.1 | 3.8 |
| 1306 | Isoascaridole | 1.5 | - |
| 1327 | Myrtenyl acetate | - | 0.2 |
| 1347 | Silphinene | - | 0.1 |
| 1350 | α-Terpinyl acetate | 0.1 | - |
| 1354 | Citronellol acetate | - | 0.3 |
| 1357 | Eugenol | 0.3 | - |
| 1364 | Neryl acetate | - | 0.2 |
| 1379 | Silphiperfol-6-ene | - | 0.1 |
| 1382 | Geranyl acetate | - | 0.8 |
| 1382 | Sabinyl propionate | - | 0.9 |
| 1392 | (E)-Jasmone | 0.5 | - |
| 1402 | Methyleugenol | 0.1 | 0.1 |
| 1412 | cis, threo-Davanafuran | 0.2 | - |
| 1414 | Sabinyl isobutanoate | - | 0.2 |
| 1483 | α-Curcumene | - | 1.0 |
| 1485 | β-Selinene | 0.5 | - |
| 1490 | Davana ether | 1.0 | - |
| 1501 | Capillene | - | 4.2 |
| 1505 | C15H22O (MW 220) | - | 0.1 |
| 1510 | Cameroonan-7α-ol | - | 0.8 |
| 1515 | Davana ether isomer | 4.3 | - |
| 1530 | Artedouglasia oxide C | 1.8 | - |
| 1535 | Artedouglasia oxide A | 3.3 | - |
| 1544 | Italicene ether | - | 0.3 |
| 1566 | Artedouglasia oxide D | 1.1 | - |
| 1573 | 1,5-Epoxysalvial-4(14)-ene | - | 1.4 |
| 1578 | Artedouglasia oxide B | 1.8 | - |
| 1580 | Spathulenol | 1.8 | 8.5 |
| 1595 | Viridiflorol | 0.9 | - |
| 1608 | β-Antlantol | - | 2.1 |
| 1639 | Capillin | - | 3.2 |
| 1655 | C15H24O (MW 220) | 2.8 | - |
| 1660 | Neointermedeol | 3.3 | - |
| 1677 | Valeranone | - | 0.7 |
| 1688 | Eudesma-4(15),7-dien-1β-ol | - | 1.1 |
| 1692 | C15H26O (MW 222) | 1.0 | - |
| 1752 | γ-Costol | 0.2 | - |
| 1776 | α-Costol | 0.4 | - |
| 1820 | (E)-Artemidin | - | 3.1 |
| 1835 | C15H20O3 (MW 248) | 0.4 | - |
| 1844 | Hexahydrofarnesyl acetone | 0.1 | - |
| 1880 | (Z)-Artemidin | - | 1.5 |
| Monoterpene hydrocarbons | 8.2 | 34.0 | |
| Oxygenated monoterpenes | 62.7 | 35.9 | |
| Sesquiterpene hydrocarbons | 0.5 | 1.2 | |
| Oxygenated sesquiterpenes | 24.4 | 19.5 | |
| Other | 1.3 | 7.6 | |
| Total | 97.1 | 98.1 |
| RRI * | Compound | A. lerchiana | A. santonicum |
|---|---|---|---|
| 1022 | Eucalyptol | 6.45 | - |
| 1070 | Glycolic acid | 0.34 | - |
| 1150 | Camphor | 4.58 | - |
| 1161 | Borneol | 3.69 | - |
| 1177 | Terpinen-4-ol | 0.2 | - |
| 1195 | Myrtenol | 1.95 | - |
| 1253 | Succinic acid | 0.1 | 0.39 |
| 1255 | Ascaridole | 1.49 | - |
| 1260 | Glycerol | 0.86 | 2.1 |
| 1265 | Octanoic acid | - | 2.27 |
| 1289 | Bornyl acetate | 0.37 | - |
| 1294 | 4-Methoxyphenol | - | 0.95 |
| 1337 | Carvacrol | 1.86 | 0.18 |
| 1340 | Glyceric acid | - | 0.45 |
| 1345 | Fumaric acid | - | 4.25 |
| 1393 | Hydroquinone | - | 1.9 |
| 1436 | trans-Cinnamic acid | - | 0.95 |
| 1461 | 4′-Hydroxyacetophenone | 0.21 | 0.42 |
| 1480 | 10-Undecenoic acid | 11.45 | - |
| 1481 | β-Selinene | 0.63 | - |
| 1498 | Malic acid | - | 5.72 |
| 1500 | Capillene | - | 1.32 |
| 1503 | meso-Erythritol | - | 0.1 |
| 1515 | Pyroglutamic acid | - | 1.63 |
| 1536 | Artedouglasia oxide A | 0.45 | - |
| 1562 | Methyl p-coumarate | 0.19 | - |
| 1578 | Erythronic acid | - | 2.45 |
| 1640 | 4-Hydroxybenzoic acid | 0.2 | 0.1 |
| 1660 | Neointermedeol | 1.23 | - |
| 1700 | Methyl 3,4-dihydroxybenzoate | - | 0.31 |
| 1774 | Costol | 0.76 | - |
| 1776 | Vanillic acid | 0.2 | 0.25 |
| 1790 | 1,2-Longidione | - | 0.83 |
| 1811 | Protocatechuic acid | 0.33 | 0.3 |
| 1813 | Pinitol | - | 3.61 |
| 1816 | 2-Ethylhexyl salicylate | 0.94 | - |
| 1845 | Fructose | 0.21 | 0.41 |
| 1849 | Quinic acid | 0.51 | 0.96 |
| 1880 | Syringic acid | 0.1 | - |
| 1940 | Hydroxycinnamic acid | 0.1 | 0.1 |
| 1972 | Glucose | 0.15 | 0.21 |
| 2042 | Hexadecanoic acid (palmitic acid) | 0.34 | 0.47 |
| 2097 | Ferulic acid | 0.21 | |
| 2126 | Myo-Inositol | 0.31 | 0.28 |
| 2137 | Caffeic acid | - | 0.3 |
| 2162 | Octadecanoic acid (stearic acid) | - | 0.14 |
| 2201 | 9,12-Octadecadienoic acid (linoleic acid) | - | 0.22 |
| 2568 | rac-Glycerol 1-palmitate | - | 0.34 |
| 2709 | Sucrose | 0.80 | 1.45 |
| 2757 | Glycerol monostearate | - | 0.20 |
| 3100 | Chlorogenic acid | - | 0.68 |
| 3149 | 6-O-Methylapigenin (hispidulin) | 0.1 | - |
| 3198 | 6-O-Hydroxyluteolin 4′,6-dimethl ether (jaceosidin) | 1.05 | - |
| 3325 | β-Amyrin | 0.1 | 0.2 |
| 3355 | α-Amyrin | 0.87 | 1.27 |
| 3402 | 6-O-Hydroxyluteolin 4′,6,7-trimethyl ether (eupatorin) | 0.94 | - |
| Studied Fraction | IC50, [μg/mL] | |
|---|---|---|
| A. lerchiana | A. santonicum | |
| Essential oils | 64.42 ± 2.69 | 14.60 ± 0.58 |
| Acetone exudates | 961 ± 0.17 | >1000 |
| Galanthamine (positive control) | 0.21 ± 0.02 | |
| Bioassay | Studied Fraction | Solvent | Tested Dose/Concentration |
|---|---|---|---|
| Inhibition of seed germination | EO | 0.1% solution Tween 40 | 0.5 to 3.0 μL/mL |
| AE | water:acetone 99.5:0.5 (v/v) | 1 to 8 mg/mL | |
| Inhibition of acetylcholinesterase | EO | Methanol | 0.001 to 1000 µg/mL |
| AE | Methanol | 0.001 to 1000 µg/mL | |
| Inhibition of phytopathogenic mycelium growth | EO | Without | 0.2 µL |
| AE | DMSO | 15 µL (100 mg/mL) |
Disclaimer/Publisher’s Note: The statements, opinions and data contained in all publications are solely those of the individual author(s) and contributor(s) and not of MDPI and/or the editor(s). MDPI and/or the editor(s) disclaim responsibility for any injury to people or property resulting from any ideas, methods, instructions or products referred to in the content. |
© 2023 by the authors. Licensee MDPI, Basel, Switzerland. This article is an open access article distributed under the terms and conditions of the Creative Commons Attribution (CC BY) license (https://creativecommons.org/licenses/by/4.0/).
Share and Cite
Nikolova, M.; Lyubenova, A.; Yankova-Tsvetkova, E.; Georgiev, B.; Berkov, S.; Aneva, I.; Trendafilova, A. Artemisia santonicum L. and Artemisia lerchiana Web. Essential Oils and Exudates as Sources of Compounds with Pesticidal Action. Plants 2023, 12, 3491. https://doi.org/10.3390/plants12193491
Nikolova M, Lyubenova A, Yankova-Tsvetkova E, Georgiev B, Berkov S, Aneva I, Trendafilova A. Artemisia santonicum L. and Artemisia lerchiana Web. Essential Oils and Exudates as Sources of Compounds with Pesticidal Action. Plants. 2023; 12(19):3491. https://doi.org/10.3390/plants12193491
Chicago/Turabian StyleNikolova, Milena, Aneta Lyubenova, Elina Yankova-Tsvetkova, Borislav Georgiev, Strahil Berkov, Ina Aneva, and Antoaneta Trendafilova. 2023. "Artemisia santonicum L. and Artemisia lerchiana Web. Essential Oils and Exudates as Sources of Compounds with Pesticidal Action" Plants 12, no. 19: 3491. https://doi.org/10.3390/plants12193491
APA StyleNikolova, M., Lyubenova, A., Yankova-Tsvetkova, E., Georgiev, B., Berkov, S., Aneva, I., & Trendafilova, A. (2023). Artemisia santonicum L. and Artemisia lerchiana Web. Essential Oils and Exudates as Sources of Compounds with Pesticidal Action. Plants, 12(19), 3491. https://doi.org/10.3390/plants12193491













